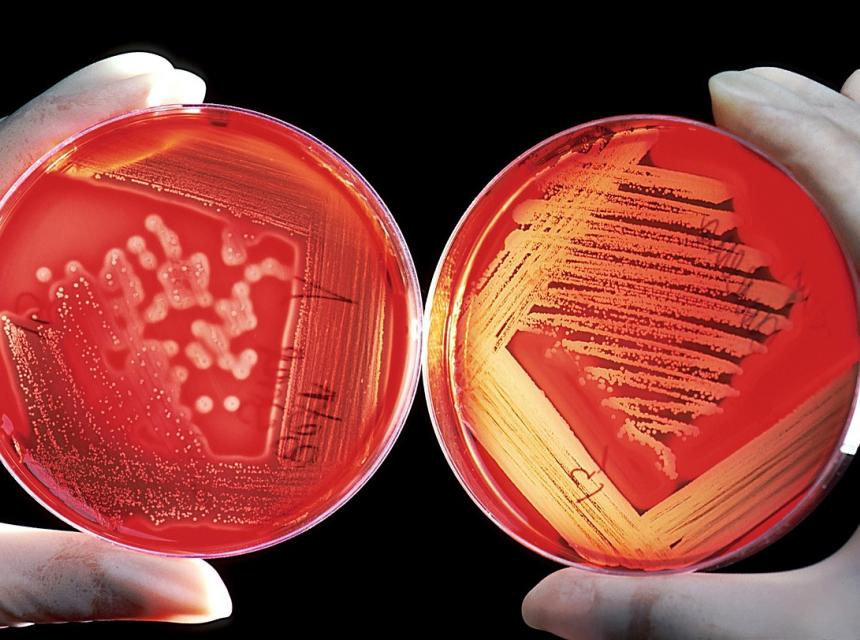
Kolonie bakterií na laboratorním sklíčku, zdroj obrázku Pixabay.com

Legionelóza láme v Česku rekordy
Nenápadná bakterie legionelly sužuje stále více Čechů, kteří kvůli ní bojují se zápaly plic nebo horečkami a kašlem. Uplynulo sotva čtvrt roku a je zřejmé, že loňský rekord v počtu nemocných bude letos překonán. Nákaza se potvrdila už u víc než dvou set lidí, oproti minulému roku je to za stejné období dvojnásobek.
Za celý loňský rok evidují hygieny 620 nakažených legionelózou neboli legionářskou nemocí, což je dosavadní rekord. O rok dříve to bylo 342 případů, dál do minulosti jsou počty znatelně nižší. Na 280 nemocných ohlásily úřady v roce 2019, o deset let dříve jich bylo pouze pětadvacet.
Každoročně na nemoc zemřou desítky lidí, v loňském roce jich bylo minimálně padesát. Riziko je to zvlášť pro seniory a osoby s oslabenou imunitou. „A těch nám v populaci přibývá. Vezměte si, kolik máme pacientů s poruchou imunity a onkologicky nemocných,“ podotkl epidemiolog Roman Chlíbek.
Choroba se šíří vdechováním kapének obsahujících bakterii legionelly. Symptomy zprvu připomínají chřipku. Nemocné bolí klouby, hlava, mají horečku a postupně se přidává kašel. Infekce se poté začne šířit v dýchacích cestách a může způsobit zápal plic. Je proto důležité včas nasadit léčbu antibiotiky.
Za strmým nárůstem vidí epidemiologové špatnou údržbu vodovodního potrubí – hlavně v koncových částech, výměnících a neudržovaných bateriích nebo sprchových hadicích –, ale i klimatizací a nedostatečný ohřev vody v bojlerech, kdy některé domácnosti ve snaze ušetřit snížily teplotu ohřívané vody až příliš.
„Legionella se přizpůsobuje, je schopna lépe přežívat a teplota vody má také svůj vliv,“ shrnul Chlíbek.
Teplou vodu je nutné prohřát na nejméně 50 °C, studená by měla být pod 20 °C.
„Teplota vody pod 50 °C podporuje růst a množení bakterie legionelly. Dle epidemiologického šetření není výjimečný ohřev teplé vody v rodinách nemocných pouze na zhruba 30 až 40 °C,“ řekla Novinkám Hana Bendíková, ředitelka protiepidemického odboru Krajské hygienické stanice Jihočeského kraje. Hlášeno mají letos 29 případů.
Totéž popisují ve Středočeském kraji, který patří s jednatřiceti nakaženými k nejvíc zasaženým. „Při takzvané termodezinfekci by měla teplota vody občas 60 °C přesáhnout,“ připomněla mluvčí středočeských hygieniků Dana Šalamunová a zdůraznila, že hromadné výskyty legionářské nemoci v rodinách, kde všichni používají stejnou sprchu, a tedy i stejně teplou vodu, neevidují. „Téměř vždy onemocní imunitně oslabený jedinec,“ dodala.
Pod náporem celý svět
Česko v nárůstu případů není samo, rostoucí počty nemocných hlásí státy napříč kontinenty, loni například Austrálie, Spojené státy nebo Španělsko. Příčiny rostoucího výskytu nemoci tak budou i jinde než jen v trubkách, byť tam se bakterie množí především.
Zdrojem mohou být také klimatizace, které si kvůli globálnímu oteplování pořizuje stále více domácností i v Česku, venkovní mlžítka ochlazující vzduch nebo třeba pára v sauně. Vědci zkoumají i riziko šíření vodní páry z chladicích věží v průmyslových areálech. Právě tam se mohou bakterie usazovat a úspěšně se živit z usazených látek, hlavně železa.
Souvislost mezi nákazou a chladicí věží se už v několika případech prokázala. Patrně šlo ale o pracovníky, kteří byli v blízkém kontaktu s aerosolem. Naposledy se tak stalo letos v západním Rakousku, kde se objevilo ohnisko s 47 nakaženými.
„Prošetřením ohniska bylo zjištěno, že pravděpodobným zdrojem této epidemie je chladicí věž,“ píše se v reportu Evropského střediska pro prevenci a kontrolu nemocí (ECDC).
Podle Dany Šalamunové je však nepravděpodobné, že by se aerosol z chladicích věží rozšířil do větších vzdáleností v takové koncentraci, aby se z něj mohl kdokoliv nakazit. Naředí se vzduchem.